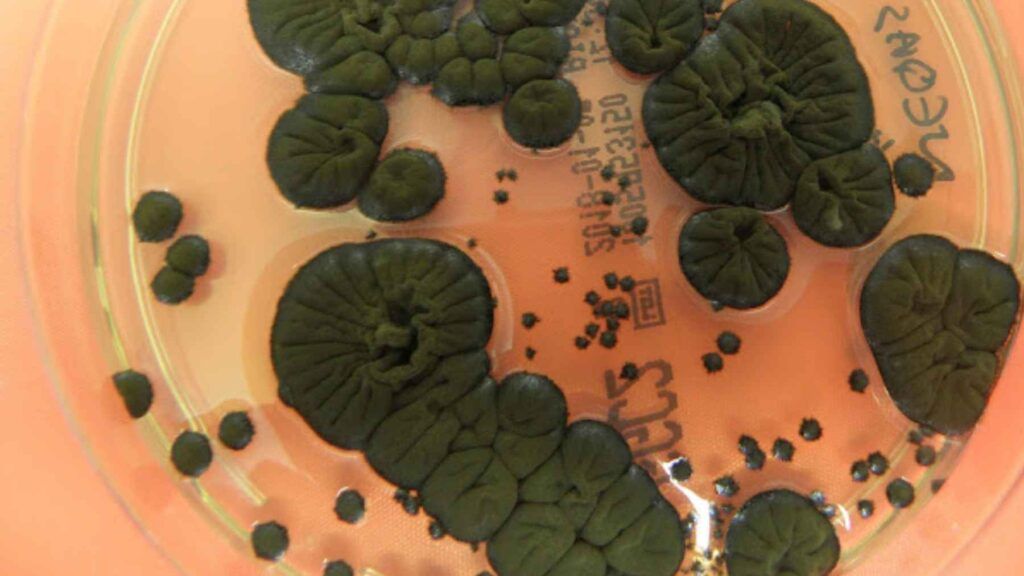

Din cuprinsul articolului
La aproape patru decenii de la dezastrul nuclear de la Cernobîl cercetătorii continuă să găsească forme de viață adaptate la un mediu considerat ostil pentru majoritatea organismelor. Una dintre cele mai studiate este o ciupercă închisă la culoare, Cladosporium sphaerospermum, care nu doar că rezistă la radiații, dar pare să își accelereze creșterea în anumite condiții.
Descoperirea a atras atenția pentru că ridică o întrebare neobișnuită: pot unele organisme să transforme radiația într-un avantaj?
Ce au arătat primele observații
Primele semnale au apărut în anii ’90, când cercetători de la Ukrainian National Academy of Sciences au identificat numeroase colonii de ciuperci în interiorul structurii care acoperă reactorul 4. Aceste organisme erau prezente chiar în zonele cele mai contaminate.
Un detaliu a ieșit rapid în evidență. Multe dintre aceste ciuperci conțineau cantități mari de melanină, pigmentul care dă culoare pielii, părului și ochilor la oameni.
Melanina era deja cunoscută pentru rolul său protector în condiții extreme, dar în acest caz părea să facă mai mult decât atât.
Experimentul care a schimbat perspectiva
Un studiu publicat în PLOS ONE în 2007 a comparat ciuperci bogate în melanină cu variante fără acest pigment. Cercetătorii le-au expus la niveluri ridicate de radiații ionizante, mult peste fondul natural.
Rezultatele au fost neașteptate. Ciupercile cu melanină au crescut mai bine în aceste condiții decât cele fără pigment. În unele cazuri, au produs mai multă biomasa și au utilizat mai eficient nutrienții.
În același timp, cercetătorii au observat că radiația modifica proprietățile electrice ale melaninei, ceea ce ar putea explica o parte din acest comportament.
Ipoteza care a apărut: „radiosinteza”
Pentru a explica fenomenul, oamenii de știință au propus un concept numit „radiosinteză”. Ideea pornește de la o comparație simplă: plantele folosesc lumina prin fotosinteză, iar aceste ciuperci ar putea utiliza, într-o anumită măsură, energia radiațiilor.
Autorii studiului au fost prudenți. Nu au afirmat că organismul „se hrănește” cu radiație în sensul clasic. Au vorbit despre un mecanism posibil, care permite o adaptare mai eficientă la un mediu agresiv.
Un comportament și mai surprinzător
Un alt studiu publicat în Mycological Research a arătat că unele ciuperci din zona Cernobîl cresc în direcția radiației. Fenomenul este numit radiotropism.
Este un comportament rar întâlnit. Se aseamănă cu modul în care plantele se orientează spre lumină, dar în acest caz „stimulentul” este radiația.
De ce interesează descoperirea dincolo de Pământ
Cercetarea nu s-a oprit la nivel teoretic. Agenții precum NASA analizează deja posibilitatea de a folosi astfel de organisme în spațiu.
Un experiment realizat la bordul International Space Station a arătat că această ciupercă a crescut mai rapid în orbită și a redus ușor nivelul radiațiilor din jurul ei.
Efectul nu este spectaculos la prima vedere, dar deschide o direcție interesantă. Materiale biologice capabile să se dezvolte singure ar putea deveni, în viitor, o soluție pentru protejarea astronauților sau a echipamentelor.
Ce înseamnă cu adevărat descoperirea
Este important de făcut o distincție clară. Ciuperca nu „anulează” radiația și nu poate transforma zonele contaminate în spații sigure.
Ceea ce arată studiile este o capacitate de adaptare neobișnuită, care merită investigată. Organismul pare să gestioneze mai eficient energia radiațiilor și să își optimizeze creșterea în aceste condiții.
Ce urmează
Cercetătorii încearcă acum să înțeleagă mecanismele exacte implicate. Dacă ipoteza legată de melanină se confirmă complet, ar putea apărea aplicații în domenii variate:
-
protecție împotriva radiațiilor
-
materiale biologice pentru construcții spațiale
-
tehnologii inspirate din procese naturale
Descoperirea legată de Cladosporium sphaerospermum schimbă modul în care este privită viața în medii extreme. Nu este vorba despre o „super-organism” care sfidează legile biologiei, ci despre o adaptare care deschide întrebări noi.
La aproape 40 de ani de la accidentul de la Chernobyl disaster, zona rămâne un laborator natural unde cercetătorii descoperă nu doar efectele radiațiilor, ci și capacitatea vieții de a găsi soluții acolo unde părea imposibil.








